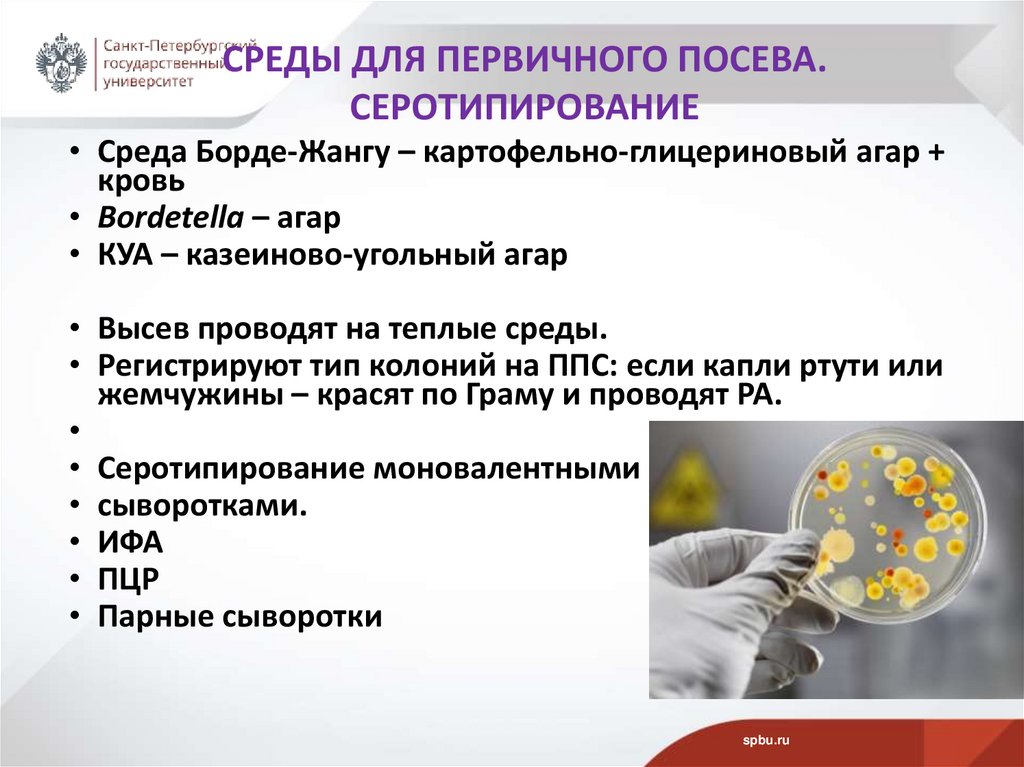

Similar presentations:
Коклюш. Возбудитель коклюша. Bordetella pertussis
1. ВОЗБУДИТЕЛЬ КОКЛЮША Bordetella pertussis
д.б.н. проф.Рыбальченко О.В.
СПбГУ
06.03.2025
2. ПЛАН
• 1. Коклюш, актуальность.• 2. Клиническая картина коклюша
• 3.Таксономия и история открытия рода Bordetella
• 4. Морфологические свойства
• 5. Культуральные свойства
• 6. Биохимические свойства и АГ структура
• 7. Факторы патогенности
• 8. Патанатомические изменения при коклюше
• 9. Лабораторная диагностика.
• 10. Иммунитет. Чувствительность к АМП. Вакцины и
прививки от коклюша
spbu.ru
3. 1 вопрос КОКЛЮШ (la coqueluche) от фр. – coq - петушиный крик
Коклюш – острое антропонозное инфекционноевысококонтагиозное заболевание, характеризующееся
приступами судорожного кашля.
По данным ВОЗ, в мире ежегодно заболевает
коклюшем около 60 млн. человек, умирает около 1 млн.
детей, преимущественно в возрасте до одного года.
spbu.ru
4. 2 вопрос ЗАРАЖЕНИЕ Bordetella pertussis
• Заражение – воздушно-капельным путем.• Источник – больной человек, заразен уже на
начальной стадии заболевания.
• Контагиозность – сохраняется 6 - 8 недель.
• Заболевание в любом возрасте, но чаще болеют
дети 2 -10 лет.
• Взрослые – переносчики инфекции
Ребенок с симптомами
коклюшной инфекции
spbu.ru
5. КЛИНИЧЕСКАЯ КАРТИНА КОКЛЮША
• Инкубационный период -7-10 до 14 дней.• 3 периода, каждый около 2-х недель:
• 1. Катаральный
• 2. Спазматический
• 3. Реконвалесценции
(разрешения)
spbu.ru
6. 1. КАТАРАЛЬНЫЙ ПЕРИОД КОКЛЮША
• Кашель не отличается по характеру от кашля приОРВИ.
• Температуры нет.
• Горло слегка гиперемировано.
• Кашель постепенно приобретает упорный
характер, усиливается, особенно сильны
приступы по ночам.
spbu.ru
7. 2. СПАЗМАТИЧЕСКИЙ ПЕРИОД КОКЛЮША
Кашель постепенно приобретает приступообразныйхарактер.
Типичный приступ кашля сопровождается
глубоким вздохом, за которым следует
кашель «стаккато» - длительный сухой кашель, отрывистый,
звонкий, приступообразный.
• На высоте приступа наступает апноэ после прекращения
спазма голосовой щели слышен глубокий вдох со свистом.
• Спустя некоторое время приступ возобновляется ребенок
становится цианотичным (цианоз).
• Очень часто приступ кашля заканчивается рвотой.
spbu.ru
8. 3. ПЕРИОД РЕКОНВАЛЕСЦЕНЦИИ
• Приступы менее частые и не так сильны.• Не осложненный коклюш проходит без
температуры.
spbu.ru
9. 3 вопрос ТАКСОНОМИЯ РОДА Bordetella (2020)
16 видов р. BordetellaНаиболее клинически значимые:
1. B. pertussis - возбудитель коклюша
2. B. parapertussis- возбудитель паракоклюша
3. B. bronchiseptica
- вызывает бронхосептикоз (патогенен для
животных, редко для человека)
Для всех видов бордетелл – различная
инфицирующая доза.
spbu.ru
10. ОТКРЫТИЕ ВОЗБУДИТЕЛЯ КОКЛЮША - Bordetella pertussis (от лат. pertussis – сильный кашель ) ОТКРЫТ В 1906 Г. Ж.БОРДЕ И О.ЖАНГУ
ОТКРЫТИЕ ВОЗБУДИТЕЛЯ КОКЛЮША Bordetella pertussis (от лат. pertussis – сильный кашель )ОТКРЫТ В 1906 Г. Ж.БОРДЕ И О.ЖАНГУ
Жюль Борде
Jules Bordet (1870-1961) –
Нобелевская премия по
физиологии и медицине 1919 г.
Октав Жангу
Octave Gengou (1875-1957)
Нобелевская премия по
физиологии и медицине 1919 г.
spbu.ru
11. ИСТОРИЯ ОТКРЫТИЯ Bordetella
• 1911 г. Н. Ферри открыла В. bronchiseptica.• В 1937 г. Эльдеринг и П. Кендрик и независимо от
них У. Брэнфорд и Б. Славин выделили и изучили
В.parapertussis.
spbu.ru
12. 4 вопрос МОРФОЛОГИЧЕСКИЕ СВОЙСТВА КЛЕТОК Bordetella
Гр(-) мелкие палочки – коккобактерии0,2-0,3 мкм ø
до 0,5-1,0 мкм в длину.
Расположены отдельно друг от друга.
Спор и истинной капсулы не образуют.
Микрокапсула.
Подвижны только B. bronchiseptica - перитрихи.
spbu.ru
13. КЛЕТКИ B. pertussis ЭЛЕКТРОННАЯ МИКРОСКОПИЯ
Позитивно окрашенныеклетки B. pertussis
СЭМ. Поверхность биопленки
B. pertussis
spbu.ru
14. 5 вопрос КУЛЬТУРАЛЬНЫЕ СВОЙСТВА B. pertussis
Облигатные паразиты человекаСтрогие аэробы. O/F тест (+/-).
Оптимальная температура 37˚С.
Требовательны к температурному фактору.
Высев следует производить на подогретые среды.
spbu.ru
15. ПИТАТЕЛЬНЫЕ СРЕДЫ ДЛЯ КУЛЬТИВИРОВАНИЯ БОРДЕТЕЛЛ
На ППС образуют колонии –"жемчужинки" капельки ртути.
Среда Борде-Жангу
(картофельноглицериновый агар
с кровью).
Среда КУА
(казеиновоугольный агар).
spbu.ru
16. СКОРОСТЬ РОСТА Bordetella ПОЯВЛЕНИЕ КОЛОНИЙ ПРИ ПЕРВИЧНОМ ПОСЕВЕ НА ППС
B. pertussisB. parapertussis
B. bronchiseptica
- 72 час
- 36- 48 час
- 18-24 час
Диаметр колоний на ППС через 72 час
B. pertussis
1-2 мм
B. parapertussis - 2-3 мм
B. bronchiseptica - 4 мм
spbu.ru
17. УСТОЙЧИВОСТЬ Bordetella ВО ВНЕШНЕЙ СРЕДЕ
• Малоустойчивы во внешней среде,• чувствительны к высушиванию,
• погибают при действии солнечного света в течение – 1
час,
• при температуре 560С – гибнут через 10-30 мин,
• в 3% растворе фенола и лизола – гибнут через несколько
минут.
• При высыхании мокроты гибнут в течение нескольких
часов.
spbu.ru
18. 6 вопрос БИОХИМИЧЕСКИЕ СВОЙСТВА клеток Bordetella
• Очень не активны в биохимическом отношении.• Ферментативная активность выражена очень слабо.
• Не расщепляют белки и углеводы.
• Не восстанавливают нитраты.
• Образуют каталазу (+).
spbu.ru
19. АГ СТРУКТУРА р. Bordetella
Один общий для рода АГ- агглютиноген 7Обще- Видовые
родовой
B. pertussis
7
Внутривидовые
(штаммовые)
1
1, 2, 3, 4, 5, 6, 13, 15, 16
B. parapertussis
14
8, 9, 10
B. bronchiseptica
12
8, 9, 10, 11
spbu.ru
20. 7 вопрос ФАКТОРЫ ПАТОГЕННОСТИ. РАЗВИТИЕ ИНФЕКЦИОННОГО ПРОЦЕССА 1 ЭТАП. АДГЕЗИЯ КЛЕТОК БОРДЕТЕЛЛ
• Гемагглютинин - адгезия возбудителя коклюша наклетках реснитчатого эпителия слизистой оболочки
дыхательных путей (гортань, трахея, бронхи) с
последующей колонизацией.
• Пертактин – токсин - белок наружной мембраны
B.pertussis играет важную роль в прикреплении к
реснитчатому эпителию дыхательных путей.
spbu.ru
21. 1 ЭТАП. АДГЕЗИЯ B. pertussis
• Прикрепление клеток B. pertussis к реснитчатомуэпителию за счет гемагглютинина и пертактина.
spbu.ru
22. 1 ЭТАП. АДГЕЗИЯ КЛЕТОК B. pertussis
spbu.ru23. 2 ЭТАП. КОЛОНИЗАЦИЯ B. pertussis
• Клетки эпителия без ресничек свободны отвозбудителя коклюша B. pertussis.
spbu.ru
24. 3 ЭТАП. ОБРАЗОВАНИЕ КЛЕТКАМИ B. pertussis ФЕРМЕНТОВ И ТОКСИНОВ
Аденилатциклаза – кальций зависимый,порообразующий цитотоксин – подавляет активность
фагоцитов.
Дерматонекротический токсин - термолабильный токсин
индуцирует локальные некротические повреждения.
Трахеальный цитотоксин - нарушение мукоцилиарного
клиренса за счет изменения функции реснитчатого
эпителия, что приводит к накоплению слизи.
Липополисахариды – фрагменты наружной мембраны
B. pertussis стимулируют выработку цитокинов и
активируют систему комплемента, вызывая местное
воспаление и повреждение слизистой оболочки
дыхательных путей.
spbu.ru
25. КОКЛЮШНЫЙ ТОКСИН (пертуссин)
Мол.Масса- 117 кДаА субъединица (S -1) и В
субъединица (S2-5)
Пертуссин - АДФ-рибозилирование
G- белка.
Нарушает ионный обмен.
Повышает проницаемость сосудов.
Приводит к некрозу эпителия.
Раздражение рецепторов кашлевой
рефлексогенной зоны - «невроз
респираторного тракта».
В ЦНС (в кашлевом центре
продолговатого мозга) формируется
доминантный очаг возбуждения,
что вызывает приступообразный
кашель.
spbu.ru
26. ФЕРМЕНТЫ-ФАКТОРЫ ПАТОГЕННОСТИ БОРДЕТЕЛЛ
Гиалуронидаза,Лецитиназа,
Плазмокоагулаза,
Лейкоцитоз- и
гистаминстимулирующие факторы.
spbu.ru
27. 8 вопрос ПАТАНАТОМИЧЕСКИЕ ИЗМЕНЕНИЯ ПРИ КОКЛЮШЕ
Существенные изменения в эпителии бронхов –некроз.
Слизистая оболочка легких также воспалена и
утолщена.
Вязкая слизь заполняет просвет мелких бронхов.
В
результате
возникают
эмфизематозные
изменения - расширение легких, повышение
содержания воздуха.
spbu.ru
28. ОСЛОЖНЕНИЯ ПРИ КОКЛЮШЕ
• Частое осложнение – тяжелая пневмония,бронхопневмония.
• Тяжелое осложнение – энцефалопатия.
• Редко - кровоизлияние в мозг.
• Упорный кашель и рвота ведет к дистрофии.
spbu.ru
29. 9 вопрос ЛАБОРАТОРНАЯ ДИАГНОСТИКА
Клинический материал – слизь из дыхательных путей(тампоном).
• Кашлевые пластинки
• Обычный тампон
• Тампон на проволоке, согнутой под углом в 45˚вниз.
spbu.ru
30.
ТАМПОН ДЛЯ ВЗЯТИЯМАТЕРИАЛА НА ПОСЕВ ЧЕРЕЗ
НОС ПРИ КОКЛЮШЕ
spbu.ru
31. СРЕДЫ ДЛЯ ПЕРВИЧНОГО ПОСЕВА. СЕРОТИПИРОВАНИЕ
• Среда Борде-Жангу – картофельно-глицериновый агар +кровь
• Bordetella – агар
• КУА – казеиново-угольный агар
• Высев проводят на теплые среды.
• Регистрируют тип колоний на ППС: если капли ртути или
жемчужины – красят по Граму и проводят РА.
• Серотипирование моновалентными
• сыворотками.
• ИФА
• ПЦР
• Парные сыворотки
spbu.ru
32. 10 вопрос ИММУНИТЕТ
После перенесенного коклюша формируется стойкийнапряженный типоспецифический антимикробный
клеточный и гуморальный иммунитет.
У новорожденных имеются материнские IgА.
Перекрестного иммунитета между B. pertussis,
B. parapertussis и B. bronchiseptica не наблюдается.
spbu.ru
33. ПОДХОДЫ К ЛЕЧЕНИЮ
• Специфический – противококлюшный иммуноглобулинчеловеческий.
• Неспецифический – назначаются антибиотики только в
тяжелых случаях и детям до 1 года (эритромицин,
стрептомицин, ампициллин, левомицетин, тетрациклин).
• Симптоматическая терапия (антигистаминные,
противосудорожные препараты и средства,
стимулирующие работу сердца, кислородотерапия,
психотерапия).
spbu.ru
34. ЧУВСТВИТЕЛЬНОСТЬ К АМП
• Эритромицин• Ампициллин
spbu.ru
35. ПРОФИЛАКТИКА КОКЛЮША
В России болеют 50% привитых детейПричины:
1. недостаточно хорошие вакцины,
2. плохая иммунокомпетентная система у детей.
23% детей болеют особенно тяжело
3. Много не привитых детей!!!
spbu.ru
36. СПЕЦИФИЧЕСКАЯ ПРОФИЛАКТИКА
• Плановая вакцинация в соответствии с национальнымкалендарем прививок вакциной АКДС (состоит из 3 доз)
• в 3- 4,5- 6 месяцев;
• ревакцинация осуществляется в 18 месяцев.
• Последующие ревакцинации в 7 и 14 лет, и каждые
последующие 10 лет проводят АДС-М анатоксином.
• Для экстренной профилактики контактным детям, не
болевшим коклюшем, вводится иммуноглобулин
человеческий нормальный (в дозе 3 мл, 2-х кратно с
интервалом 24 часа) с последующим наблюдением
(карантин) в течение 14 дней.
spbu.ru
37. ВАКЦИНА АКДС
А-адсорбированная (на сорбенте)К- коклюшно (1х1010 клеток/1мл)
Д-дифтерийно- (30 Международных единиц (МИЕ)
С- столбнячная (60 МИЕ)
Сорбент — гидроксид алюминия
(0,25–0,55 мг/мл),
консервант — мертиолят (0,05 мг/мл)
Вакцинация с 3-х мес.
• В вакцине коклюшная часть - убитые клетки
Bordetella pertussis – могут вызывать аллергию !!!
• Разработана вакцина с коклюшным анатоксином –
защищает только от токсина.
spbu.ru
38. ВАКЦИНЫ
• Кроме АКДС - еще ряд вакцин:• «Тетракок» (коклюш, дифтерия, столбняк и полиомиелит),
«Д.Т.Вакс» и «ДТ-адюльт» (АДС), «Бубо-Кок» (АКДС+гепатит В),
«Тританрикс НВ», «Пентавак», «Гексавак», «Триацелювакс»,
«АаКДС».
• Инфанрикс - бесклеточная вакцина для профилактики коклюша,
дифтерии и столбняка (Бельгия).
• Тетраксим): 4 компонента (против коклюша, дифтерии,
столбняка и полиомиелита) (Франция).
• Пентаксим : 5 компонентов (против коклюша, дифтерии,
столбняка, полиомиелита и ХИБ-инфекции -Haemophilus
influenzae тип b), (Франция).
spbu.ru

medicine
medicine








